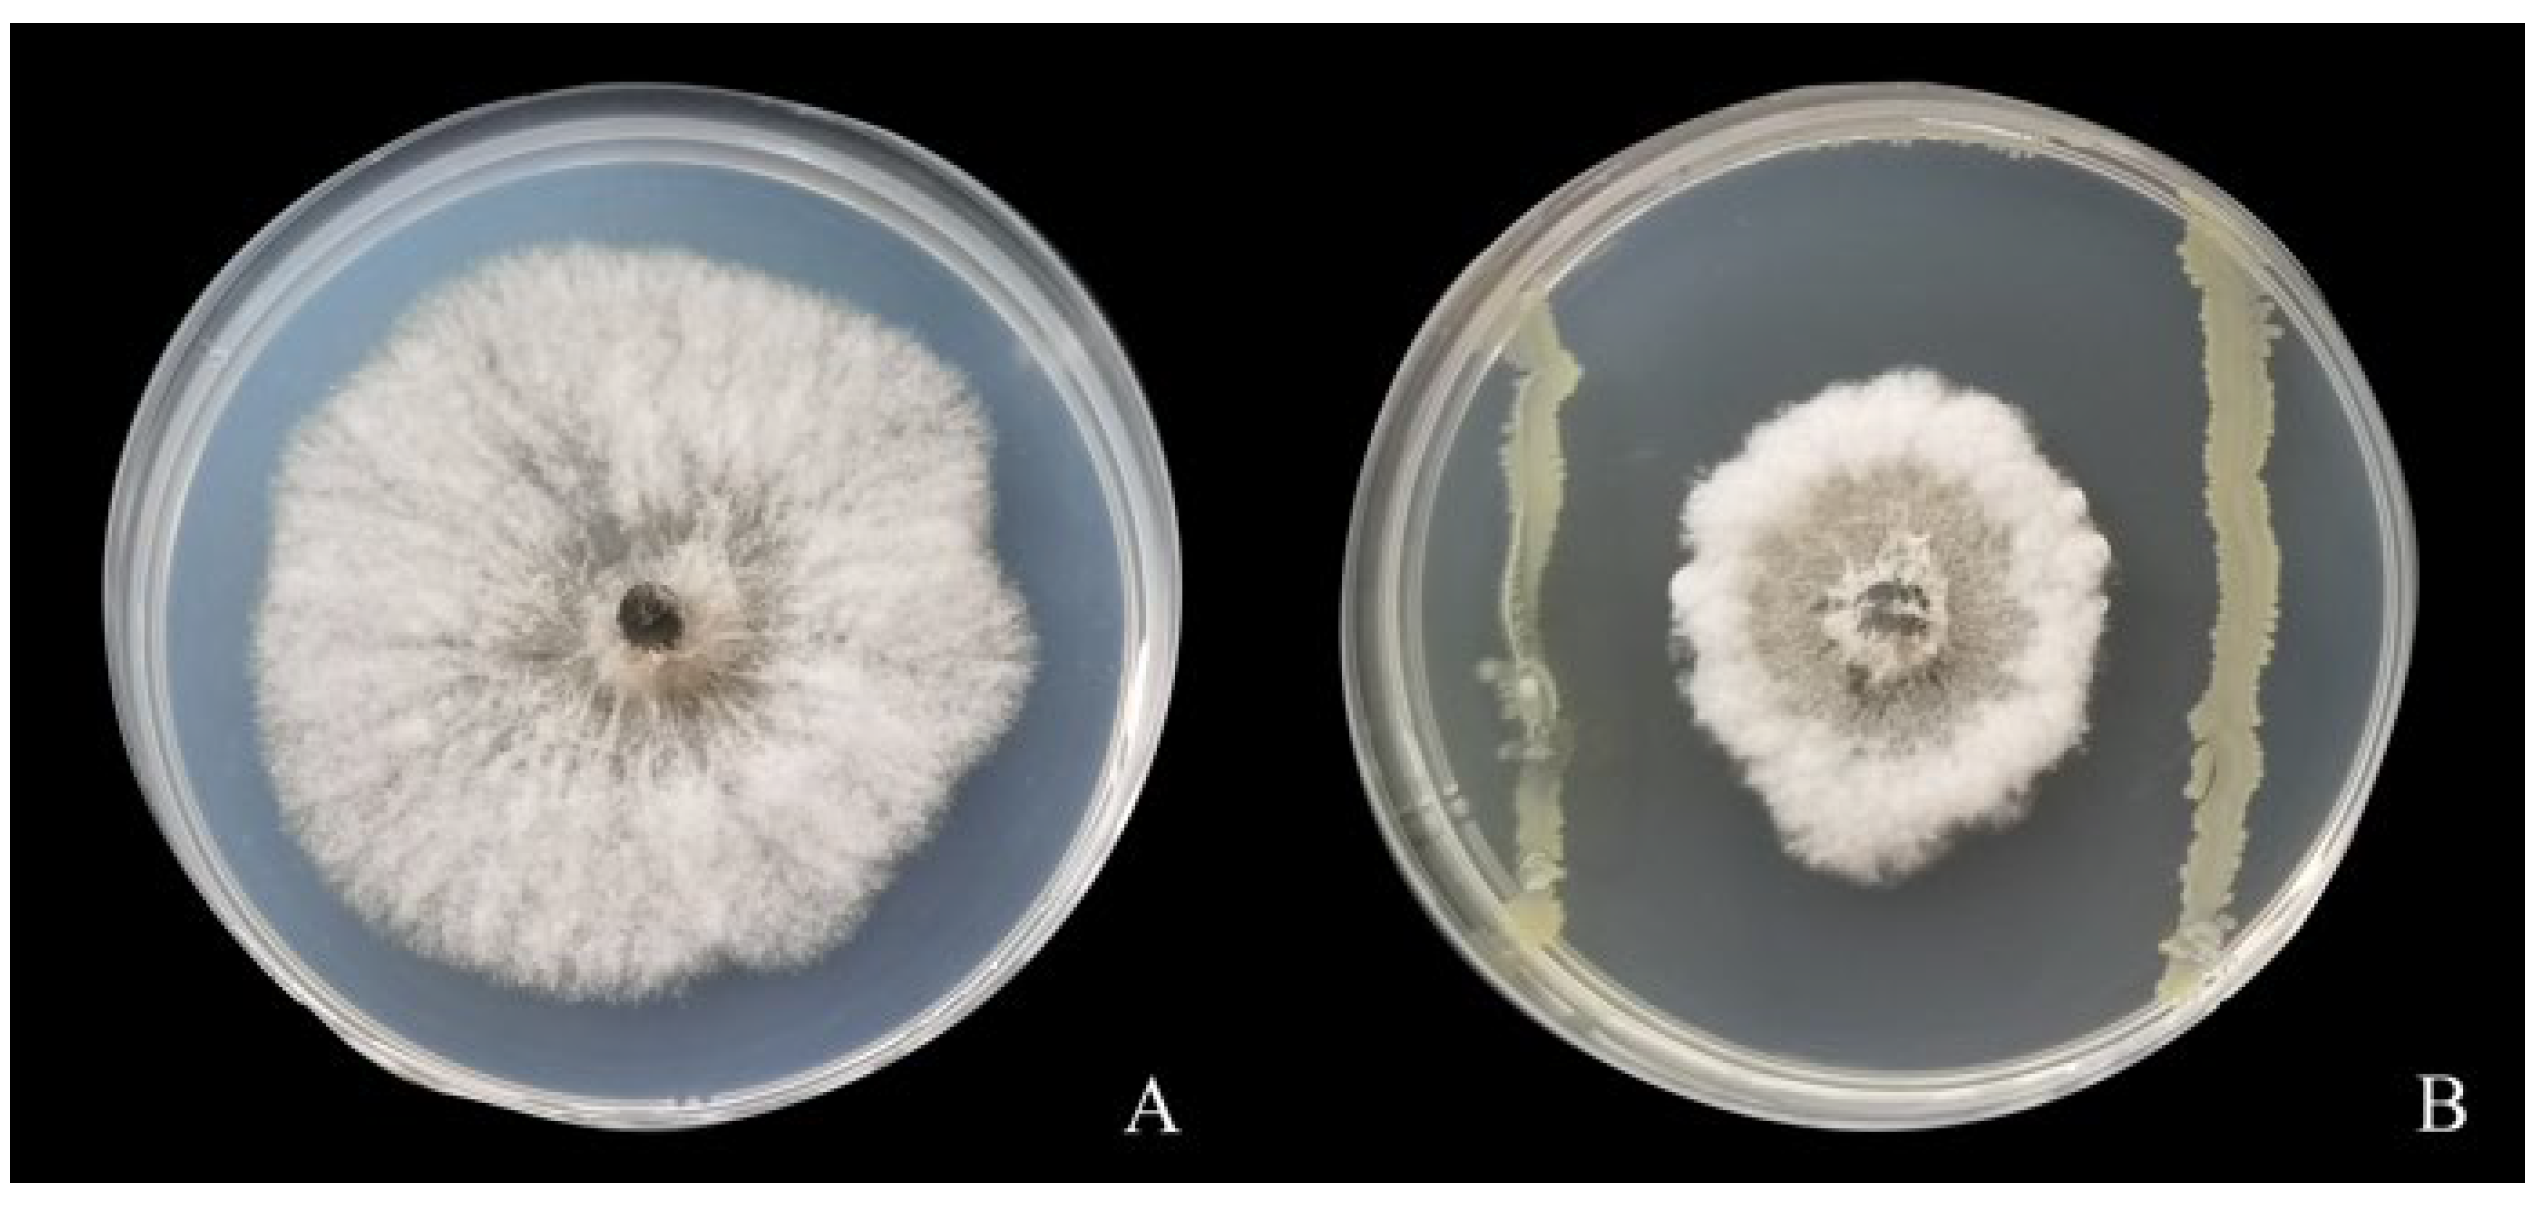
Fermentation 09 00482 g001 Fermentation 09 00482 g001
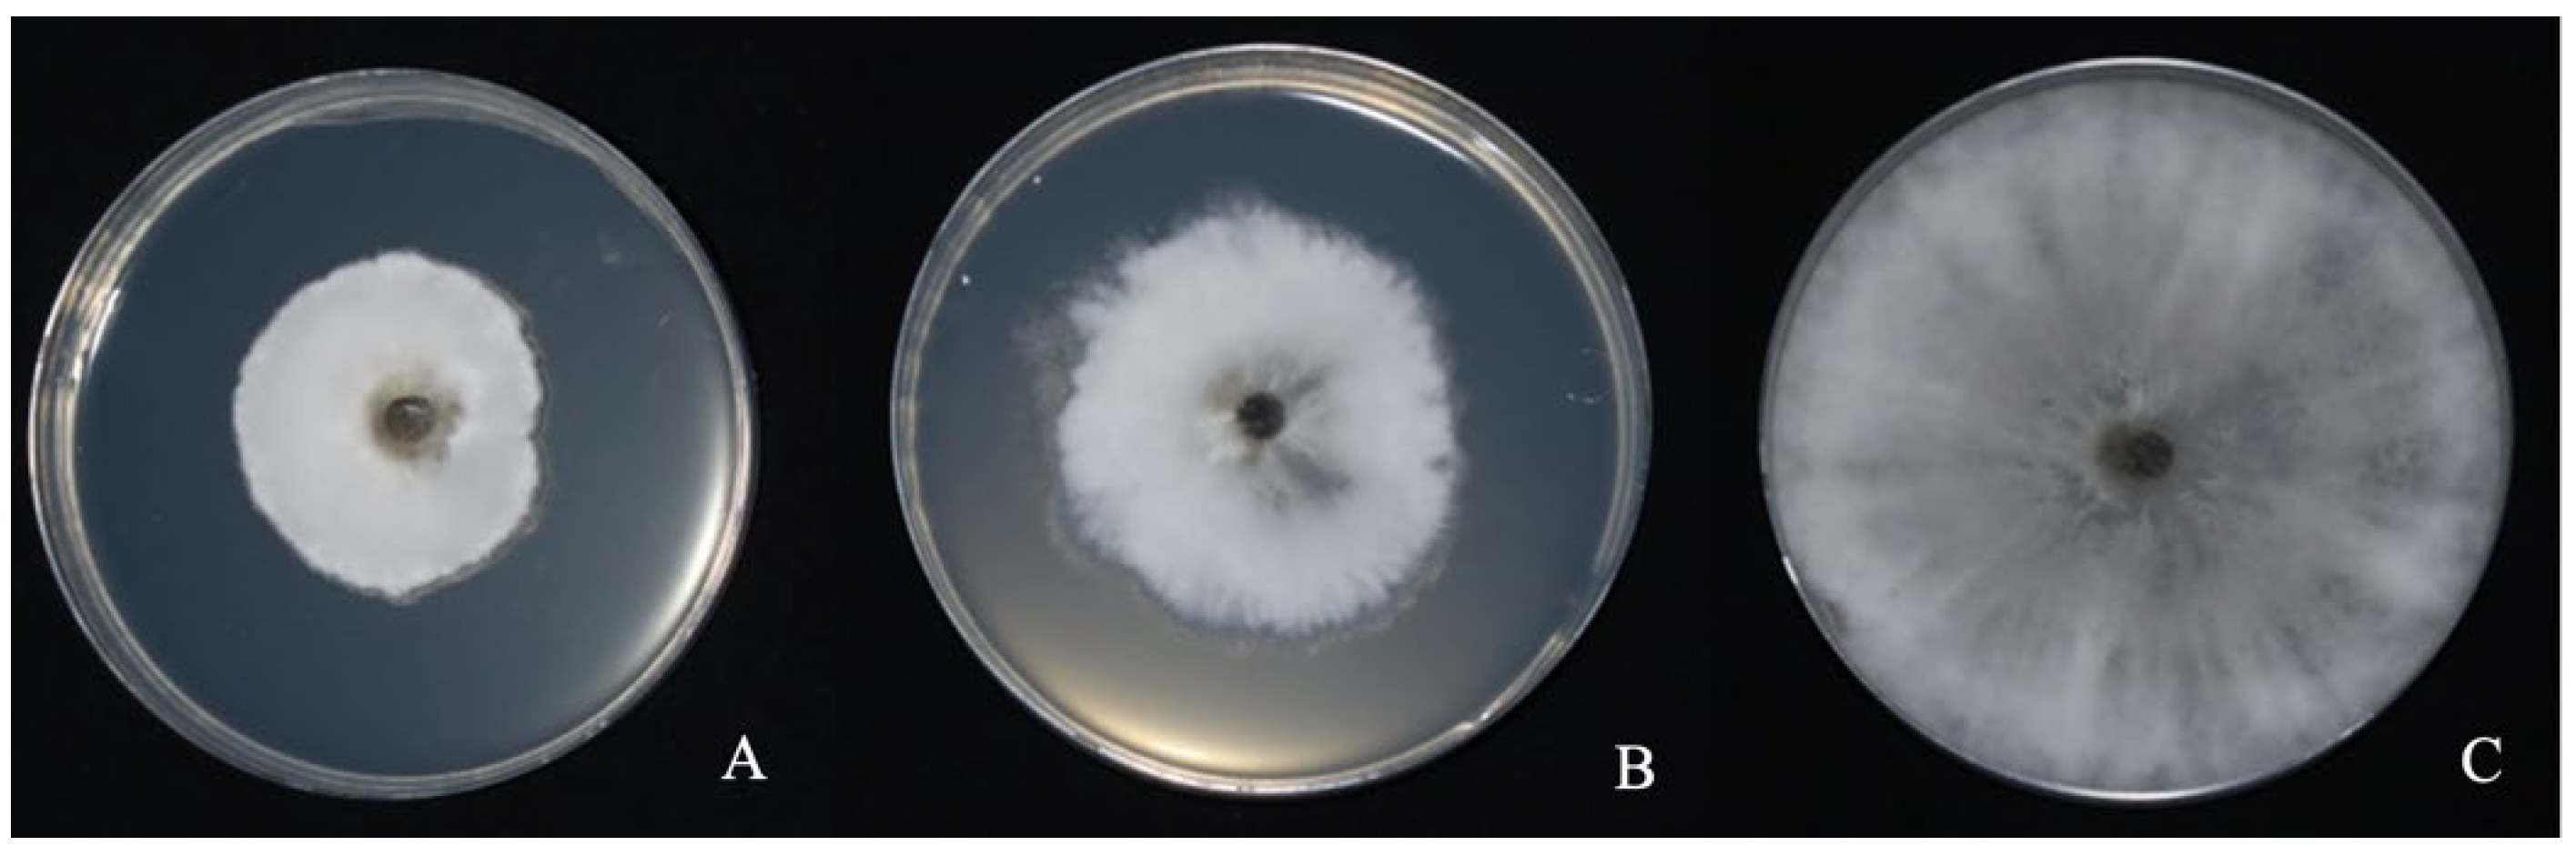
Fermentation 09 00482 g009 Fermentation 09 00482 g009

Optimization of Fermentation Conditions for Bacillus pumilus LYMC-3 to Antagonize Sphaeropsis sapinea
Abstract
1. Introduction
2. Materials and Methods
2.1. Preparation of Test Materials
2.1.1. Source of Test Medium and Strain
2.1.2. Strain Activation, Preparation of Seed Solution and Acquisition of Fermentation Broth, Fermentation Filtrate and Bacterial Suspension
2.2. Plate Antagonism Test on Strain LYMC-3 against Sphaeropsis sapinea
2.2.1. Plate Standoff Method
2.2.2. Mycelial Growth Rate Method
2.3. Greenhouse Efficacy Test of Strain LYMC-3 against Pine Blight Disease
2.4. Single-Factor Optimization Test of Strain LYMC-3 Fermentation Conditions
2.4.1. Optimization of Culture Medium Components
2.4.2. Optimization of Culture Conditions
2.5. Response Surface Optimization Test on LYMC-3 Fermentation Conditions
2.5.1. Plackett–Burman (PB) Trial
2.5.2. Steepest Climb Test
2.5.3. Box–Behnken Design
2.5.4. Response Surface Optimization
2.5.5. Comparison of Fungal Inhibition Ability of Strain LYMC-3 before and after Medium Optimization
2.6. Data Analysis and Processing
3. Results and Analysis
3.1. Antagonistic Activity of Strain LYMC-3 against S. sapinea
3.2. Greenhouse Efficacy of Strain LYMC-3 against Pine Dieback Disease
3.3. Optimization of Strain LYMC-3 Medium Components
3.3.1. Effect of Different Carbon Sources on the Growth of S. sapinea
3.3.2. Effect of Different Nitrogen Sources on the Growth of S. sapinea
3.3.3. Effect of Different Inorganic Salts on the Growth of S. sapine
3.4. Optimization Results of Culture Conditions of Strain LYMC-3
3.5. Response Surface Optimization Results of Strain LYMC-3 Culture Conditions
3.5.1. PB Trial
3.5.2. The Steepest Climbing Test
3.5.3. BBD Experiments
3.6. Comparison of Strain LYMC-3 Fungal Inhibition Ability before and after Medium Optimization
4. Discussion
5. Conclusions
Author Contributions
Funding
Institutional Review Board Statement
Informed Consent Statement
Data Availability Statement
Conflicts of Interest
References
- Swart, W.J.; Knox-Davies, P.S.; Wingfield, M.J. Sphaeropsis sapinea, with special reference to its occurrence on Pinus spp. in South Africa. J. S. Afr. For. Assoc. 1986, 135, 1–8. [Google Scholar]
- Wu, X.Q. Occurence and control countermeasure of Sphaeropsis sapinea shoot blight on conifer in the world. World For. Res. 1999, 12, 16–21. [Google Scholar]
- Xie, X.; Lliang, J.; Zhu, Y.P.; Hu, R.R.; Chen, Y.Y.; Zhang, X.Y. Diversity and community structure of endophytic fungi in the pure forest of pinus densiflorainfected by different incidences of Sphaeropsis sapinea. Sci. Silvae Sin. 2020, 56, 51–57. [Google Scholar]
- Blumenstein, K.; Bukamp, J.; Langer, G.J.; Schler, R.; Terhonen, E. Sphaeropsis sapinea and associated endophytes in Scots pine: Interactions and effect on the host under variable water content. Front. For. Glob. Chang. 2021, 4, 655769. [Google Scholar] [CrossRef]
- Bukamp, J.; Blumenstein, K.; Terhonen, E.; Langer, G.J. Differences in the virulence of Sphaeropsis sapinea strains originating from Scots pine and non-pine hosts. For. Pathol. 2021, 51, e12712. [Google Scholar]
- Xinyi, C.; Yuanyuan, Z.; Xuechi, F.; Yan, L.; Qi, W. Isolation and characterization of Bacillus amyloliquefaciens PG12 for the biological control of apple ring rot. Postharvest Biol. Technol. 2016, 115, 113–121. [Google Scholar]
- Mahaffee, W.F.; Kloepper, J.W. Temporal changes in the bacterial communities of soil, rhizosphere, and endorhiza associated with field-grown cucumber (Cucumis sativus L.). Microb. Ecol. 1997, 34, 210–223. [Google Scholar] [CrossRef]
- Xu, M.; Zhang, X.; Yu, J.; Guo, Z.; Wan, S. Biological control of peanut southern blight (Sclerotium rolfsii) by the strain Bacillus pumilus LX11. Biocontrol Sci. Technol. 2020, 30, 485–489. [Google Scholar] [CrossRef]
- Mohit, A.; Shrivardhan, D.; Ramesh, C.; Dubey, P.; Kumar, D. Differential antagonistic responses of Bacillus pumilus MSUA3 against Rhizoctonia solani and Fusarium oxysporum causing fungal diseases in Fagopyrum esculentum Moench. Microbiol. Res. 2017, 205, 40–47. [Google Scholar]
- Sha, Y.; Zeng, Q.; Sui, S. Screening and application of Bacillus strains isolated from nonrhizospheric rice soil for the biocontrol of rice blast. Plant Pathol. J. 2020, 36, 231–243. [Google Scholar] [CrossRef]
- Abd-El-Kareem, F.; Elshahawy, I.E.; Abd-Elgawad, M.M.M. Application of Bacillus pumilus isolates for management of black rot disease in strawberry. Egypt. J. Biol. Pest Control 2021, 31, 25. [Google Scholar] [CrossRef]
- Huang, X.; Nan, Z.; Yong, X.; Yang, X.; Shen, Q. Biocontrol of Rhizoctonia solani damping-off disease in cucumber with Bacillus pumilus SQR-N43. Microbio. Res. 2012, 167, 135–143. [Google Scholar] [CrossRef] [PubMed]
- Zheng, L.; Ma, X.; Lang, D.; Zhang, X.; Zhou, L.; Wang, L.; Zhang, X. Encapsulation of Bacillus pumilus G5 from polyvinyl alcoholsodium alginate (PVA-SA) and its implications in improving plant growth and soil fertility under drought and salt soil conditions. Int. J. Biol. Macromol. 2022, 209, 231–243. [Google Scholar] [CrossRef] [PubMed]
- Bonifer, K.S.; Wen, X.; Hasim, S.; Phillips, E.K.; Reynolds, T.B. Bacillus pumilus B12 degrades polylactic acid and degradation is affected by changing nutrient conditions. Front. Microbiol. 2019, 10, 2548. [Google Scholar] [CrossRef] [PubMed]
- Li, L.; Tan, J.; Chen, F. Bacillus pumilus strain LYMC-3 shows nematicidal activity against Bursaphelenchus xylophilus via the production of a guanidine compound. Biocontrol Sci. Technol. 2018, 28, 1128–1139. [Google Scholar] [CrossRef]
- Li, L.L.; Tan, J.J.; Chen, F.M. Colonization of GFP-tagged Bacillus pumilus strain LYMC-3 in masson pine. J. Huazhong Agric. Univ. 2016, 35, 68–73. [Google Scholar] [CrossRef]
- Pan, M.; Zhu, M.L.; Tan, J.J.; Li, L.L.; Hao, D.J. The antagonism of Bacillus pumilus LYMC⁃3 strain on Phomopsis macrospora. J. Nanjing For. Univ. 2022, 46, 151–156. [Google Scholar] [CrossRef]
- Amann, R.I.; Ludwig, W.; Schleifer, K.H. Phylogenetic identification and in situ detection of individual microbial cells without cultivation. Microbiol. Rev. 1995, 59, 143–169. [Google Scholar] [CrossRef]
- Tu, Q.; Chen, J.; Guo, J. Screening and identification of antagonistic bacteria with potential for biological control of Penicillium italicum of citrus fruits. Sci. Hortic. 2013, 150, 125–129. [Google Scholar] [CrossRef]
- Xian, Z.A.; Hl, A.; Xk, A.; Sl, B.; Fl, A. Isolation, identification and optimization of fermentation conditions against Sclerotinia sclerotiorum strains in high salt Doenjang. Food Sci. Hum. Wellness 2021, 10, 205–213. [Google Scholar]
- Xue, Y.Y.; Fan, W.Y.; Zhang, S.W.; Xu, B.L. Screening, identification and biocontrol effect of antagonistic Actinomycetes against the pathogen of Cytospora sp. for apple tree. J. Appl. Ecol. 2016, 27, 3379–3386. [Google Scholar]
- Zhang, M.J.; Zheng, X.R.; Li, H.; Chen, F.M. Alternaria alternata, the causal agent of a new needle blight disease on Pinus bungeana. J. Fungi 2023, 9, 71. [Google Scholar] [CrossRef] [PubMed]
- Liu, J.; Li, X.; Yang, Y.; Wei, H.; Xue, L.; Min, Z.; Jinxiu, C. Optimization of combined microwave and hot air drying technology for purple cabbage by Response Surface Methodology (RSM). Food Sci. Nutr. 2021, 87, 2980–2998. [Google Scholar] [CrossRef] [PubMed]
- Tao, A.; Feng, X.; Sheng, Y.; Song, Z. Optimization of the artemisia polysaccharide fermentation process by Aspergillus niger. Front. Nutr. 2022, 9, 842766. [Google Scholar] [CrossRef] [PubMed]
- Wu, Z.; Miao, W.; Yang, Y.; Fan, G.; Wu, C.; Li, T.; Xie, C.; Shen, D. Preparation of monascus-fermented ginkgo seeds: Optimization of fermentation parameters and evaluation of bioactivity. Food Sci. Biotechnol. 2022, 31, 721–730. [Google Scholar] [CrossRef]
- Daghaghele, S.; Kiasat, A.R.; Safieddin Ardebili, S.M.; Mirzajani, R. Intensification of extraction of antioxidant compounds from moringa oleifera leaves using ultrasound-assisted approach: BBD-RSM design. Int. J. Fruit Sci. 2021, 21, 693–705. [Google Scholar] [CrossRef]
- Zhang, H.M.; Zheng, L.Y.; Wang, J.C.; Zhu, F.; Niu, D.D. Screening of biocontrol bacteria for rice sheath blight and their relations with the formation of infection cushion of the pathogen. J. Plant Prot. 2021, 48, 289–297. [Google Scholar] [CrossRef]
- Cao, N.; Zhu, W.B.; Hhuang, Q.; Liu, X.F. Antibacterial activity study of two antagonistic bacteria of Dothiorella gregaria. For. Eng. 2021, 37, 72–78. [Google Scholar] [CrossRef]
- Zhang, M.M.; Liang, J.Y.; Wang, Q.F.; Du, Y.F.; Zhang, J.; Liu, Q.J.; Peng, J.F.; Fu, B. Identification and control efficiency of biocontrol bacteria against tobacco black shank. J. Henan Agric. Univ. 2022, 56, 219–227. [Google Scholar]
- Santra, H.K.; Banerjee, D. Bioactivity study and metabolic profiling of Colletotrichum alatae LCS1, an endophyte of club moss Lycopodium clavatum L. PLoS ONE 2022, 17, e0267302. [Google Scholar] [CrossRef]
- He, S.; Wang, H.; Wu, B.; Zhou, H.; Zhu, P.; Yang, R.; Yan, X. Response surface methodology optimization of fermentation conditions for rapid and efficient accumulation of macrolactin A by marine Bacillus amyloliquefaciens ESB-2. Molecules 2012, 18, 408–417. [Google Scholar] [CrossRef] [PubMed]
- Touratier, F.; Legendre, L.; Vézina, A. Model of bacterial growth influenced by substrate C:N ratio and concentration. Aquat. Microb. Ecol. 1999, 19, 105–118. [Google Scholar] [CrossRef]
- Li, R.F.; Xu, Y. Fermentation optimization to improve production of antagonistic metabolites by Bacillus subtilis strain BS501a. J. Cent. South Univ. Technol. 2011, 18, 1047–1053. [Google Scholar] [CrossRef]
- Yousten, A.A.; Wallis, D.A.; Singer, S. Effect of oxygen on growth, sporulation, and mosquito larval toxin formation by Bacillus sphaericus 1593. Curr. Microbiol. 1984, 11, 175–178. [Google Scholar] [CrossRef]
- Xin, L.; Hao, L.; Ling, M. Optimization of fermentation conditions of antibacterial substances produced by Bacillus amyloliquefaciens HRH_(317). China Brew. 2017, 36, 25–29. [Google Scholar]
- Zhang, W.; Wei, L.; Xu, R.; Lin, G.; Xin, H.; Lv, Z.; Qian, H.; Shi, H. Evaluation of the antibacterial material production in the fermentation of Bacillus amyloliquefaciens-9 from whitespotted bamboo shark (Chiloscyllium plagiosum). Mar. Drugs 2020, 18, 119. [Google Scholar] [CrossRef]
- He, F.; Chao, J.; Yang, D.; Zhang, X.; Yang, C.; Xu, Z.; Jiewei, T.; Yongqiang, T. Optimization of fermentation conditions for production of neutral metalloprotease by Bacillus subtilis SCK6 and its application in goatskin-dehairing. Prep. Biochem. Biotechnol. 2021, 52, 789–799. [Google Scholar] [CrossRef]
- Serrano, N.; Rodrigues, L.; Hokka, C.; Sousa, C.; Teixeira, J.; Mussatto, S. Optimal glucose and inoculum concentrations for production of bioactive molecules by Paenibacillus polymyxa RNC-D. Chem. Pap. 2012, 66, 1111–1117. [Google Scholar] [CrossRef]
- Dai, Y.; Wang, Y.-H.; Li, M.; Zhu, M.-L.; Wen, T.-Y.; Wu, X.-Q. Medium optimization to analyze the protein composition of Bacillus pumilus HR10 antagonizing Sphaeropsis sapinea. AMB Expr. 2022, 12, 61. [Google Scholar] [CrossRef]

| Treatments | Infection Rate (%) | Mortality Rate (%) | Disease Index | Prevention and Treatment Effect (%) |
|---|---|---|---|---|
| Fermentation filtrate | 16.67 | 0 | 6.67 | 89.99 |
| Fermentation solution | 33.33 | 16.67 | 23.33 | 65.01 |
| Bacterial suspension | 33.33 | 16.67 | 30 | 63.99 |
| CK1 | 100 | 83.33 | 83.33 | / |
| CK2 | 83.33 | 66.67 | 66.67 | / |
| Treatment No. | Factor | Level | |
|---|---|---|---|
| −1 | 1 | ||
| A | Glucose concentration (g/L) | 7 | 10.5 |
| B | Peptone concentration (g/L) | 15 | 22.5 |
| C | MgSO4 concentration (g/L) | 7 | 10.5 |
| D | Fermentation temperature (°C) | 28 | 37 |
| E | Initial pH | 7 | 8 |
| F | Inoculation amount (%) | 1 | 2 |
| G | Liquid volume (%) | 50 | 60 |
| Sources of Variance | Coefficient Estimate | Stdized Effect | Sum of Squares | Degrees of Freedom | Mean Square | F Values | p Values | Contribution | Inference | Importance Ranking |
|---|---|---|---|---|---|---|---|---|---|---|
| Model | 157.986 | 7 | 22.5695 | 17.5107 | 0.0075 | Significant | ||||
| A—glucose concentration | 1.93 | 3.8654 | 44.825 | 1 | 44.8247 | 34.7775 | 0.0041 | 27.4759 | 1 | |
| B—peptone concentration | 1.26 | 2.5167 | 19.001 | 1 | 19.0013 | 14.7423 | 0.0185 | 11.6471 | 4 | |
| C—MgSO4 concentration | 1.78 | 3.5590 | 38.020 | 1 | 38.0201 | 29.4981 | 0.0056 | 23.3049 | 2 | |
| D—fermentation temperature | 0.847 | 1.6943 | 8.6116 | 1 | 8.6116 | 6.6814 | 0.0610 | 5.27861 | 6 | |
| E—initial pH | −0.564 | −1.1285 | 3.821 | 1 | 3.8208 | 2.9644 | 0.1602 | 2.34199 | 7 | |
| F—inoculation amount | 1.07 | 2.1455 | 13.809 | 1 | 13.8091 | 10.7139 | 0.0307 | 8.46446 | 5 | |
| G—liquid volume | 1.58 | 3.1569 | 29.899 | 1 | 29.8987 | 23.1971 | 0.0085 | 18.3268 | 3 |
| Treatment No. | Glucose Concentration g/L | MgSO4 Concentration g/L | Loading Volume % | Inhibition Rate % |
|---|---|---|---|---|
| 1 | 6.6 | 6.6 | 42 | 59.827 ± 2.808 |
| 2 | 6.8 | 6.8 | 46 | 66.709 ± 1.944 |
| 3 | 7 | 7 | 50 | 74.962 ± 3.722 |
| 4 | 7.2 | 7.2 | 54 | 80.235 ± 2.821 |
| 5 | 7.4 | 7.4 | 58 | 62.148 ± 3.223 |
| 6 | 7.6 | 7.6 | 62 | 58.927 ± 3.016 |
| Sources of Variance | Sum of Squares | df | Mean Square | F Value | p Value | Inference |
|---|---|---|---|---|---|---|
| Model | 747.14 | 9 | 83.02 | 21.41 | 0.0003 ** | Significant |
| A—glucose concentration | 19.59 | 1 | 19.59 | 5.05 | 0.0594 | |
| B—MgSO4 concentration | 39.39 | 1 | 39.39 | 10.16 | 0.0153 * | |
| C—liquid volume | 107.78 | 1 | 107.78 | 27.8 | 0.0012 ** | |
| AB | 5.22 | 1 | 5.22 | 1.35 | 0.2841 | |
| AC | 8.56 | 1 | 8.56 | 2.21 | 0.181 | |
| BC | 43.32 | 1 | 43.32 | 11.17 | 0.0124 * | |
| A2 | 311.68 | 1 | 311.68 | 80.39 | <0.0001 ** | |
| B2 | 150.26 | 1 | 150.26 | 38.75 | 0.0004 ** | |
| C2 | 19.54 | 1 | 19.54 | 5.04 | 0.0596 | |
| Residual | 27.14 | 7 | 3.88 | |||
| Lack of Fit | 14.86 | 3 | 4.95 | 1.61 | 0.3198 | Not significant |
| Pure Error | 12.28 | 4 | 3.07 | |||
| Cor Total | 774.28 | 16 |
Disclaimer/Publisher’s Note: The statements, opinions and data contained in all publications are solely those of the individual author(s) and contributor(s) and not of MDPI and/or the editor(s). MDPI and/or the editor(s) disclaim responsibility for any injury to people or property resulting from any ideas, methods, instructions or products referred to in the content. |
© 2023 by the authors. Licensee MDPI, Basel, Switzerland. This article is an open access article distributed under the terms and conditions of the Creative Commons Attribution (CC BY) license (https://creativecommons.org/licenses/by/4.0/).
Share and Cite
Pan, M.; Wang, Y.; Tan, J.; Liu, F.; Hu, J. Optimization of Fermentation Conditions for Bacillus pumilus LYMC-3 to Antagonize Sphaeropsis sapinea. Fermentation 2023, 9, 482. https://doi.org/10.3390/fermentation9050482
Pan M, Wang Y, Tan J, Liu F, Hu J. Optimization of Fermentation Conditions for Bacillus pumilus LYMC-3 to Antagonize Sphaeropsis sapinea. Fermentation. 2023; 9(5):482. https://doi.org/10.3390/fermentation9050482
Chicago/Turabian StylePan, Min, Yanru Wang, Jiajin Tan, Fei Liu, and Jiafeng Hu. 2023. "Optimization of Fermentation Conditions for Bacillus pumilus LYMC-3 to Antagonize Sphaeropsis sapinea" Fermentation 9, no. 5: 482. https://doi.org/10.3390/fermentation9050482
APA StylePan, M., Wang, Y., Tan, J., Liu, F., & Hu, J. (2023). Optimization of Fermentation Conditions for Bacillus pumilus LYMC-3 to Antagonize Sphaeropsis sapinea. Fermentation, 9(5), 482. https://doi.org/10.3390/fermentation9050482





